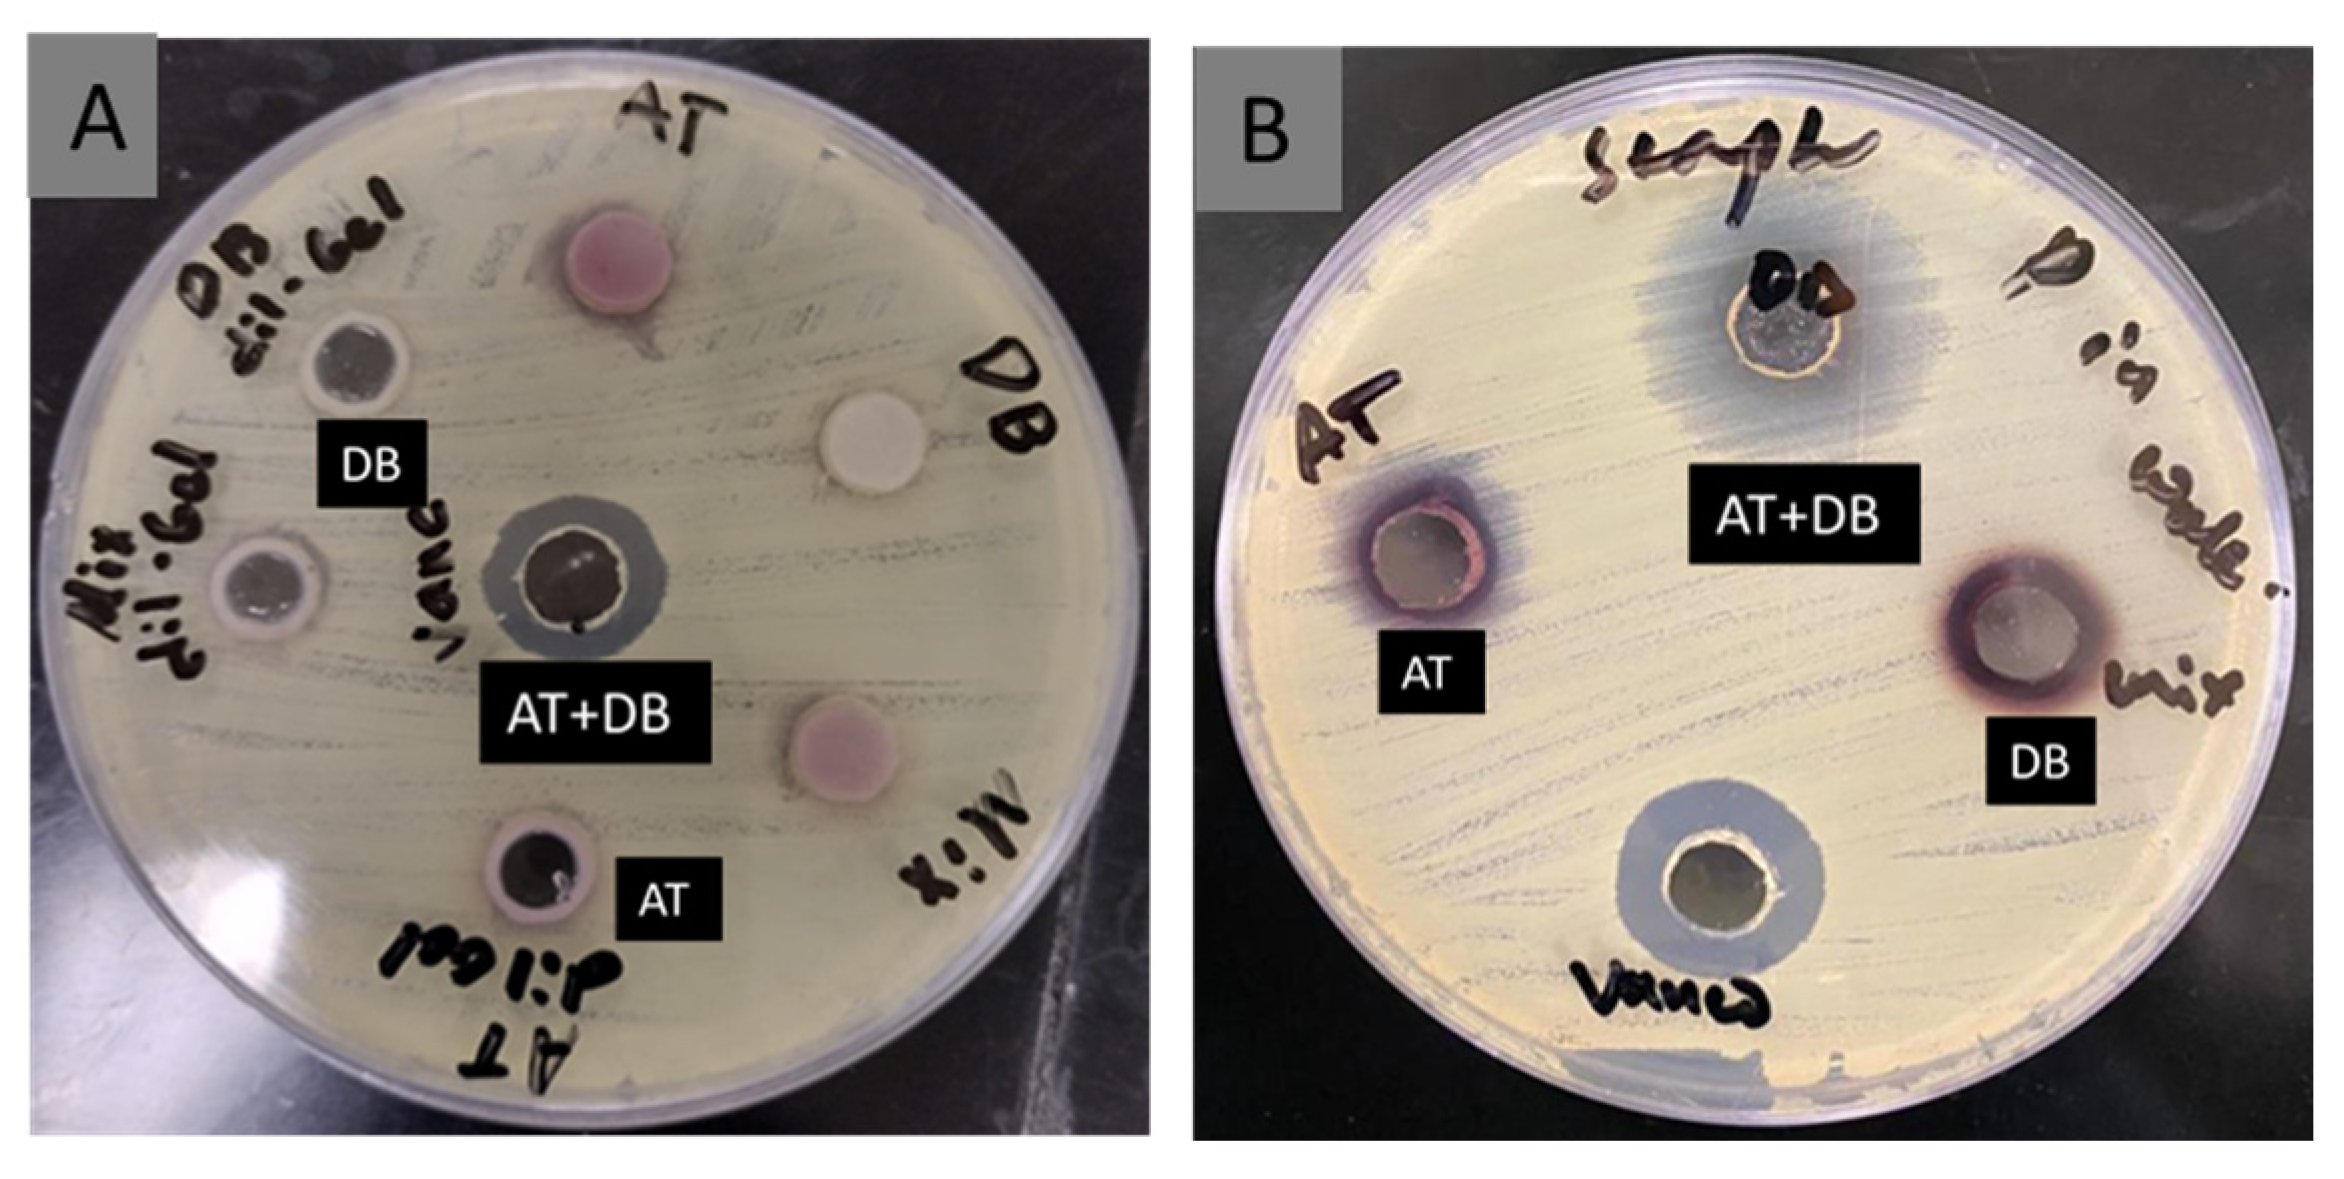
Pharmaceutics 16 00704 g006

Co-Delivery of Dragon’s Blood and Alkanna tinctoria Extracts Using Electrospun Nanofibers: In Vitro and In Vivo Wound Healing Evaluation in Diabetic Rat Model
Abstract
1. Introduction
2. Materials and Methods
2.1. Materials
2.2. Preparation of AT and DB Extracts
2.3. Preparation of Extracts Co-Loaded Electrospun NFs
2.4. Scanning Electron Microscopy and Diameter Assessment
2.5. UV-Visible Spectrophotometry
2.6. Loading Capacity and Entrapment Efficiency of the Extract-Loaded NFs
2.7. X-ray Powder Diffraction (XRPD)
2.8. Water Solubility of the Electrospun NFs
2.9. In Vitro Extract Release
2.10. Antibacterial Activity
2.11. In Vivo Wound Healing Study
2.11.1. Experimental Design of Wound Healing Study
2.11.2. Histopathological Analysis
2.12. Data Analysis:
3. Results and Discussion
3.1. Surface Morphology and Diameter Characterization
3.2. Electrospun NF Solubility Study
3.3. Loading Capacity and Entrapment Efficiency of the Extract-Loaded NFs
3.4. XRD Analysis
3.5. The In Vitro Release Study
3.6. Antibacterial Activity
3.7. In Vivo Wound Healing
3.8. Histopathological Examination
4. Conclusions
Author Contributions
Funding
Institutional Review Board Statement
Informed Consent Statement
Data Availability Statement
Conflicts of Interest
References
- Lotfy, M.; Adeghate, J.; Kalasz, H.; Singh, J.; Adeghate, E. Chronic complications of diabetes mellitus: A mini review. Curr. Diabetes Rev. 2017, 13, 3–10. [Google Scholar] [CrossRef]
- Ong, K.L.; Stafford, L.K.; McLaughlin, S.A.; Boyko, E.J.; Vollset, S.E.; Smith, A.E.; Dalton, B.E.; Duprey, J.; Cruz, J.A.; Hagins, H.; et al. Global, regional, and national burden of diabetes from 1990 to 2021, with projections of prevalence to 2050: A systematic analysis for the Global Burden of Disease Study 2021. Lancet 2023, 402, 203–234. [Google Scholar] [CrossRef]
- Al-Rubeaan, K.; Youssef, A.M.; Ibrahim, H.M.; Al-Sharqawi, A.H.; AlQumaidi, H.; AlNaqeb, D.; Aburisheh, K.H. All-cause mortality and its risk factors among type 1 and type 2 diabetes mellitus in a country facing diabetes epidemic. Diabetes Res. Clin. Pract. 2016, 118, 130–139. [Google Scholar] [CrossRef] [PubMed]
- Chammas, N.K.; Hill, R.L.R.; Edmonds, M.E. Increased Mortality in Diabetic Foot Ulcer Patients: The Significance of Ulcer Type. J. Diabetes Res. 2016, 2016, 2879809. [Google Scholar] [CrossRef]
- Alshammary, S.; Othman, S.A.; Alshammari, E.; Alarfaj, M.A.; Lardhi, H.A.; Amer, N.M.; Elsaid, A.S.; Alghamdi, H.M. Economic impact of diabetic foot ulcers on healthcare in Saudi Arabia: A retrospective study. Ann. Saudi Med. 2020, 40, 425–435. [Google Scholar] [CrossRef] [PubMed]
- Varani, J.; Warner, R.L.; Gharaee-Kermani, M.; Phan, S.H.; Kang, S.; Chung, J.; Wang, Z.; Datta, S.C.; Fisher, G.J.; Voorhees, J.J. Vitamin A antagonizes decreased cell growth and elevated collagen-degrading matrix metalloproteinases and stimulates collagen accumulation in naturally aged human skin. J. Investig. Dermatol. 2000, 114, 480–486. [Google Scholar] [CrossRef] [PubMed]
- Wear-Maggitti, K.; Lee, J.; Conejero, A.; Schmidt, A.M.; Grant, R.; Breitbart, A. Use of topical RAGE in diabetic wounds increased neovascularization and granular tissue formation. Ann. Plast. Surg. 2004, 52, 512–522. [Google Scholar]
- PePeng, Y.; Ma, Y.; Bao, Y.; Liu, Z.; Chen, L.; Dai, F.; Li, Z. Electrospun PLGA/SF/artemisinin composite nanofibrous membranes for wound dressing. Int. J. Biol. Macromol. 2021, 184, 153–162. [Google Scholar]
- Bharathi Suganya, B.; Stalin, T. Cerium oxide and peppermint oil loaded polyethylene oxide/graphene oxide electrospun nanofibrous mats as antibacterial wound dressings. Mater. Today Commun. 2019, 21, 100664. [Google Scholar] [CrossRef]
- Ghorbani, M.; Soghra, S.; Rashidi, M. Fabrication of honey-loaded ethylcellulose/gum tragacanth nanofibers as an effective antibacterial wound dressing. Colloids Surf. A Physicochem. Eng. 2021, 621, 126615. [Google Scholar] [CrossRef]
- Yang, J.; Xu, L. Electrospun Nanofiber Membranes with Various Structures for Wound Dressing. Materials 2023, 16, 6021. [Google Scholar] [CrossRef] [PubMed]
- Chen, K.; Pan, H.; Ji, D.; Li, Y.; Duan, H.; Pan, W. Curcumin-loaded sandwich-like nanofibrous membrane prepared by electrospinning technology as wound dressing for accelerate wound healing. Mater. Sci. Eng. 2021, 127, 112245. [Google Scholar] [CrossRef]
- Jiang, Z.; Zheng, Z.; Yu, S.; Gao, Y.; Ma, J.; Huang, L.; Yang, L. Nanofiber scaffolds as drug delivery systems promoting wound healing. Pharmaceutics 2023, 15, 1829. [Google Scholar] [CrossRef]
- Irani, M.; Abadi, P.G.; Ahmadian-Attari, M.M.; Rezaee, A.; Kordbacheh, H.; Goleij, P. In vitro and in vivo studies of Dragon’s blood plant (D. cinnabari)-loaded electrospun chitosan/PCL nanofibers: Cytotoxicity, antibacterial, and wound healing activities. Int. J. Biol. Macromol. 2024, 257, 128634. [Google Scholar] [CrossRef]
- Maleki, H.; Doostan, M.; Khoshnevisan, K.; Baharifar, H.; Maleki, S.A.; Fatahi, M.A. Zingiber officinale and thymus vulgaris extracts co-loaded polyvinyl alcohol and chitosan electrospun nanofibers for tackling infection and wound healing promotion. Heliyon 2024, 10, e23719. [Google Scholar] [CrossRef] [PubMed]
- Namjoyan, F.; Kiashi, F.; Moosavi, Z.B.; Saffari, F.; Makhmalzadeh, B.S. Efficacy of Dragon’s blood cream on wound healing: A randomized, double-blind, placebo-controlled clinical trial. J. Tradit. Complement. Med. 2016, 6, 37–40. [Google Scholar] [CrossRef]
- Gümüş, K.; Karaman Özlü, Z. The effect of a beeswax, olive oil and Alkanna tinctoria (L.) Tausch mixture on burn injuries: An experimental study with a control group. Complement. Ther. Med. 2017, 34, 66–73. [Google Scholar] [CrossRef]
- Karayannopoulou, M.; Tsioli, V.; Loukopoulos, P.; Anagnostou, T.L.; Giannakas, N.; Savvas, I.; Papazoglou, L.G.; Kaldrymidou, E. Evaluation of the effectiveness of an ointment based on Alkannins/Shikonins on second intention wound healing in the dog. Can. J. Vet. Res. 2011, 75, 42–48. [Google Scholar] [PubMed]
- Kheiri, A.; Amini, S.; Javidan, A.N.; Saghafi, M.M.; Khorasani, G. The effects of Alkanna tinctoria Tausch on split-thickness skin graft donor site management: A randomized, blinded placebo-controlled trial. BMC Complement. Altern. Med. 2017, 17, 253. [Google Scholar] [CrossRef]
- Alamer, A.A.; Alshehri, A.A.; Aodah, A.H.; Almughem, F.A.; Alghmadi, H.A.; Alali, A.S.; Halwani, A.A.; Ahmed, M.M.; Tawfik, E.A. Development and evaluation of sildenafil/glycyrrhizin-loaded nanofibers as a potential novel buccal delivery system for erectile dysfunction. Saudi Pharm. J. 2024, 32, 102038. [Google Scholar] [CrossRef]
- Alwahibi, M.S.; Perveen, K. Chemical analysis by GC-MS and in vitro antibacterial activity of Alkanna tinctoria extracts against skin infection causing bacteria. Biomed. Res. 2017, 28, 7946–7949. [Google Scholar]
- Tawfik, E.A.; Alshamsan, A.; Kalam, M.A.; Raish, M.; Alkholief, M.; Stapleton, P.; Harvey, K.; Craig, D.Q.; Barker, S.A. In vitro and in vivo biological assessment of dual drug-loaded coaxial nanofibers for the treatment of corneal abrasion. Int. J. Pharm. 2021, 604, 120732. [Google Scholar] [CrossRef] [PubMed]
- CLSI M07-A9; Methods for Dilution Antimicrobial Susceptibility Tests for Bacteria That Grow Aerobically, Approved Standard. CLSI document M07-A9; Clinical and Laboratory Standards Institute: Wayne, PA, USA, 2012.
- Akinlade, O.M.; Owoyele, B.V.; Soladoye, A.O. Streptozotocin-induced type 1 and 2 diabetes in rodents: A model for studying diabetic cardiac autonomic neuropathy. Afr. Health Sci. 2021, 21, 719–727. [Google Scholar] [CrossRef] [PubMed]
- Anand, S.; Rajinikanth, P.S.; Arya, D.K.; Pandey, P.; Gupta, R.K.; Sankhwar, R.; Chidambaram, K. Multifunctional Biomimetic Nanofibrous Scaffold Loaded with Asiaticoside for Rapid Diabetic Wound Healing. Pharmaceutics 2022, 14, 273. [Google Scholar] [CrossRef] [PubMed]
- Ewaldz, E.; Brettmann, B. Molecular interactions in electrospinning: From polymer mixtures to supramolecular assemblies. ACS Appl. Polym. Mater. 2019, 1, 298–308. [Google Scholar] [CrossRef]
- Alamer, A.A.; Alsaleh, N.B.; Aodah, A.H.; Alshehri, A.A.; Almughem, F.A.; Alqahtani, S.H.; Alfassam, H.A.; Tawfik, E.A. Development of Imeglimin Electrospun Nanofibers as a Potential Buccal Antidiabetic Therapeutic Approach. Pharmaceutics 2023, 15, 1208. [Google Scholar] [CrossRef]
- Aburayan, W.S.; Alajmi, A.M.; Alfahad, A.J.; Alsharif, W.K.; Alshehri, A.A.; Booq, R.Y.; Alsudir, S.A.; Alsulaihem, F.M.; Bukhary, H.A.; Badr, M.Y.; et al. Melittin from bee venom encapsulating electrospun fibers as a potential antimicrobial wound dressing patches for skin infections. Pharmaceutics 2022, 14, 725. [Google Scholar] [CrossRef] [PubMed]
- Alkahtani, M.E.; Aodah, A.H.; Abu Asab, O.A.; Basit, A.W.; Orlu, M.; Tawfik, E.A. Fabrication and Characterization of Fast-Dissolving Films Containing Escitalopram/Quetiapine for the Treatment of Major Depressive Disorder. Pharmaceutics 2021, 13, 891. [Google Scholar] [CrossRef] [PubMed]
- Alshaya, H.A.; Alfahad, A.J.; Alsulaihem, F.M.; Aodah, A.H.; Alshehri, A.A.; Almughem, F.A.; Alfassam, H.A.; Aldossary, A.M.; Halwani, A.A.; Bukhary, H.A.; et al. Fast-Dissolving Nifedipine and Atorvastatin Calcium Electrospun Nanofibers as a Potential Buccal Delivery System. Pharmaceutics 2022, 14, 358. [Google Scholar] [CrossRef]
- Giram, P.S.; Shitole, A.; Nande, S.S.; Sharma, N.; Garnaik, B. Fast dissolving moxifloxacin hydrochloride antibiotic drug from electrospun Eudragit L-100 nonwoven nanofibrous Mats. Mater. Sci. Eng. C 2018, 92, 526–539. [Google Scholar] [CrossRef]
- Zhao, L.; Orlu, M.; Williams, G.R. Electrospun Fixed Dose Combination Fibers for the Treatment of Cardiovascular Disease. Int. J. Pharm. 2021, 599, 120426. [Google Scholar] [CrossRef] [PubMed]
- Bukhary, H.; Williams, G.R.; Orlu, M. Electrospun Fixed Dose Formulations of Amlodipine Besylate and Valsartan. Int. J. Pharm. 2018, 549, 446–455. [Google Scholar] [CrossRef] [PubMed]
- Macdonald, K.E.; Boeckh, S.; Stacey, H.J.; Jones, J.D. The microbiology of diabetic foot infections: A meta-analysis. BMC Infect. Dis. 2021, 21, 770. [Google Scholar] [CrossRef] [PubMed]
- Khan, U.A.; Rahman, H.; Qasim, M.; Hussain, A.; Azizllah, A.; Murad, W.; Khan, Z.; Anees, M.; Adnan, M. Alkanna tinctoria leaves extracts: A prospective remedy against multidrug resistant human pathogenic bacteria. BMC Complement. Altern. Med. 2015, 15, 127. [Google Scholar] [CrossRef] [PubMed]
- Zheng, X.; Chen, L.; Zeng, W.; Liao, W.; Wang, Z.; Tian, X.; Fang, R.; Sun, Y.; Zhou, T. Antibacterial and Anti-biofilm Efficacy of Chinese Dragon’s Blood Against Staphylococcus aureus Isolated From Infected Wounds. Front. Microbiol. 2021, 12, 672943. [Google Scholar] [CrossRef]
- Hirapara, H.N.; Ghori, V.M.; Anovadiya, A.P.; Tripathi, C.R. Evaluation of wound healing activity of cow urine ark in diabetic Wistar albino rats. J. Intercult. Ethnopharmacol. 2016, 5, 434–438. [Google Scholar] [CrossRef]
- Merrell, J.G.; McLaughlin, S.W.; Tie, L.; Laurencin, C.T.; Chen, A.F.; Nair, L.S. Curcumin-loaded poly(epsilon-caprolactone) nanofibres: Diabetic wound dressing with anti-oxidant and anti-inflammatory properties. Clin. Exp. Pharmacol. Physiol. 2009, 36, 1149–1156. [Google Scholar] [CrossRef]
- Kumar, M.; Hilles, A.R.; Ge, Y.; Bhatia, A.; Mahmood, S. A review on polysaccharides mediated electrospun nanofibers for diabetic wound healing: Their current status with regulatory perspective. Int. J. Biol. Macromol. 2023, 234, 123696. [Google Scholar] [CrossRef]
- Kaur, K.; Sharma, R.; Singh, A.; Attri, S.; Arora, S.; Kaur, S.; Bedi, N. Pharmacological and analytical aspects of alkannin/shikonin and their derivatives: An update from 2008 to 2022. Chin. Herbal Med. 2022, 14, 511–527. [Google Scholar] [CrossRef]
- El-Banna, A.H.; Youssef, F.S.; Youssef Elzorba, H.; Soliman, A.M.; Mohamed, G.G.; Ismail, S.H.; Mousa, M.R.; Elbanna, H.A.; Osman, A.S. Evaluation of the wound healing effect of neomycin-silver nano-composite gel in rats. Int. J. Immunopathol. Pharmacol. 2022, 36, 03946320221113486. [Google Scholar] [CrossRef]

| Microorganism | Concentration (w/v%) | Zone of Inhibition (mm) | ||
|---|---|---|---|---|
| DB | AT | DB-AT Mix | ||
| S. aureus | 1.0 | 21 | 27 | 29 |
| S. aureus | 0.5 | 17 | 21 | 25 |
| P. aeruginosa | 1.0 | 20 | 19 | 22 |
| P. aeruginosa | 0.5 | 17 | 17 | 19 |
| Microorganism | MIC (%w/v) | ||
|---|---|---|---|
| DB | AT | DB-AT Mix | |
| S. aureus | 0.06 | 0.12 | 0.01 |
| P. aeruginosa | 0.06 | 0.25 | 0.03 |
Disclaimer/Publisher’s Note: The statements, opinions and data contained in all publications are solely those of the individual author(s) and contributor(s) and not of MDPI and/or the editor(s). MDPI and/or the editor(s) disclaim responsibility for any injury to people or property resulting from any ideas, methods, instructions or products referred to in the content. |
© 2024 by the authors. Licensee MDPI, Basel, Switzerland. This article is an open access article distributed under the terms and conditions of the Creative Commons Attribution (CC BY) license (https://creativecommons.org/licenses/by/4.0/).
Share and Cite
AlMotawa, R.Y.; Alhamid, G.; Badran, M.M.; Orfali, R.; Alomrani, A.H.; Tawfik, E.A.; Alzahrani, D.A.; Alfassam, H.A.; Ghaffar, S.; Fathaddin, A.; et al. Co-Delivery of Dragon’s Blood and Alkanna tinctoria Extracts Using Electrospun Nanofibers: In Vitro and In Vivo Wound Healing Evaluation in Diabetic Rat Model. Pharmaceutics 2024, 16, 704. https://doi.org/10.3390/pharmaceutics16060704
AlMotawa RY, Alhamid G, Badran MM, Orfali R, Alomrani AH, Tawfik EA, Alzahrani DA, Alfassam HA, Ghaffar S, Fathaddin A, et al. Co-Delivery of Dragon’s Blood and Alkanna tinctoria Extracts Using Electrospun Nanofibers: In Vitro and In Vivo Wound Healing Evaluation in Diabetic Rat Model. Pharmaceutics. 2024; 16(6):704. https://doi.org/10.3390/pharmaceutics16060704
Chicago/Turabian StyleAlMotawa, Rana Y., Ghadeer Alhamid, Mohamed M. Badran, Raha Orfali, Abdullah H. Alomrani, Essam A. Tawfik, Dunia A. Alzahrani, Haya A. Alfassam, Safina Ghaffar, Amany Fathaddin, and et al. 2024. "Co-Delivery of Dragon’s Blood and Alkanna tinctoria Extracts Using Electrospun Nanofibers: In Vitro and In Vivo Wound Healing Evaluation in Diabetic Rat Model" Pharmaceutics 16, no. 6: 704. https://doi.org/10.3390/pharmaceutics16060704
APA StyleAlMotawa, R. Y., Alhamid, G., Badran, M. M., Orfali, R., Alomrani, A. H., Tawfik, E. A., Alzahrani, D. A., Alfassam, H. A., Ghaffar, S., Fathaddin, A., Al-Taweel, A., & Almomen, A. (2024). Co-Delivery of Dragon’s Blood and Alkanna tinctoria Extracts Using Electrospun Nanofibers: In Vitro and In Vivo Wound Healing Evaluation in Diabetic Rat Model. Pharmaceutics, 16(6), 704. https://doi.org/10.3390/pharmaceutics16060704

